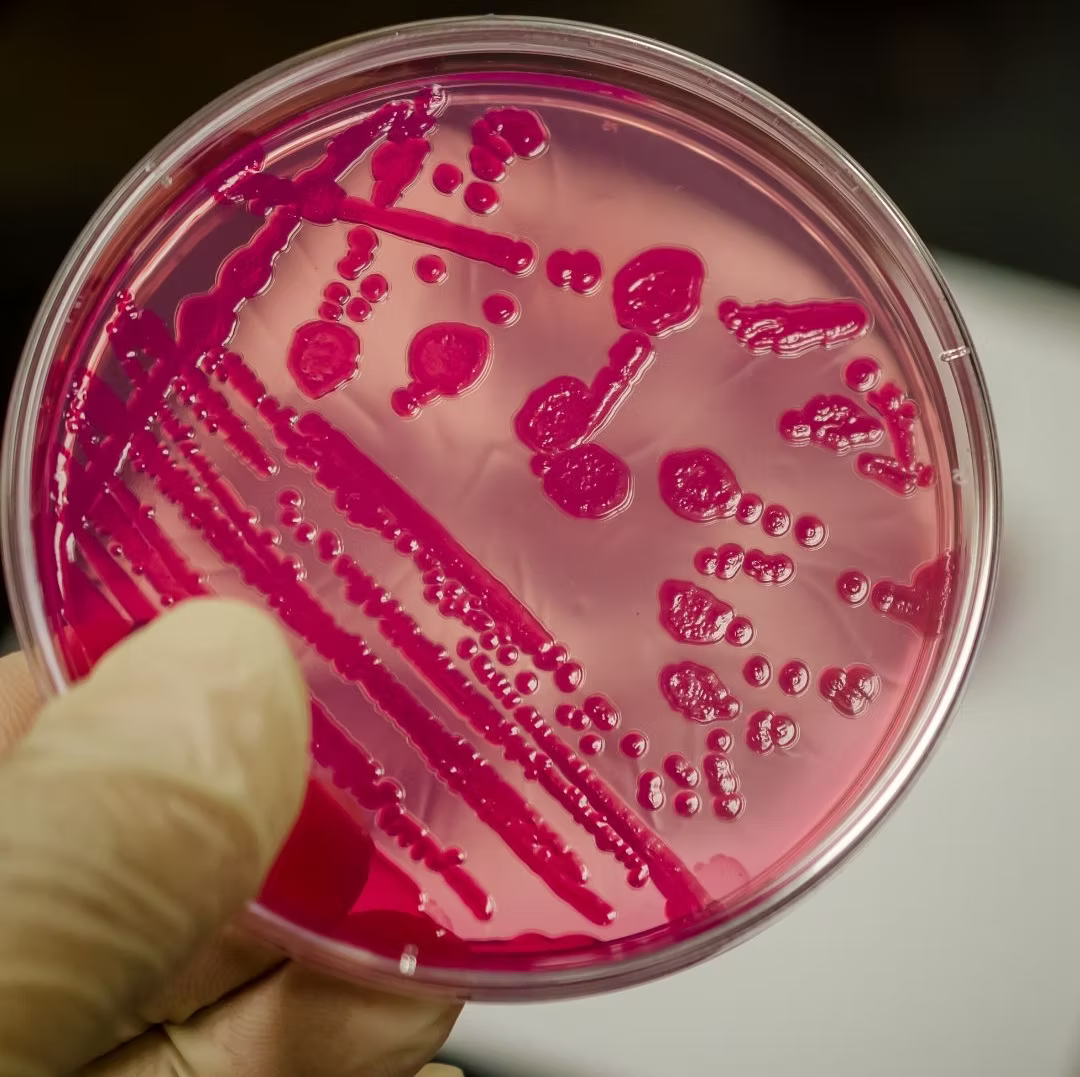
SalmoCheck – Kotuntersuchung auf Salmonellen bei Hühnern

SalmoCheck – Kotuntersuchung auf Salmonellen bei Hühnern
inkl. MwSt.
inkl. MwSt. & GRATIS Versand ab 69 €*
- Einfach schnell zu Hause durchführen – ohne Stress für Tier & Halter
- Zuverlässige Analyse innerhalb von 72 Stunden
- Geeignet zur Kontrolle der Eihygiene bei Legehennen und Fleischhygiene bei Mast- und Schlachttieren
- Ergebnis direkt per E-Mail
Lieferzeit 3-4 Werktage

Optionen auswählen

inkl. MwSt.
Mit einfacher Stallbeprobung schnell Klarheit gewinnen
Salmonellen spielen in der Geflügelhaltung eine wichtige Rolle – sowohl für die Gesundheit der Tiere als auch für die Lebensmittelsicherheit bei Eiern und Fleisch. Besonders bei Legehennen, Mast- und Schlachttieren ist es sinnvoll zu wissen, ob der Bestand mit Salmonellen belastet ist.
Der SalmoCheck ist ein Laborcheck zur Untersuchung auf Salmonellen beim Huhn. Statt einzelne Tiere zu fangen, wird eine Stallprobe mit sogenannten Boot-Swabs genommen. So erhältst du ein Bild über die Belastung des gesamten Stalles, ohne deine Hühner zu stressen.
Der Test eignet sich sowohl für Hobbyhalter als auch für kleinere gewerbliche Bestände & Mobilstallhalter die die eigene Eihygiene oder Fleischhygiene im Blick behalten möchten. Das Ergebnis erhältst du direkt per E-Mail
Eine Untersuchung auf Salmonellen ist immer dann sinnvoll, wenn du die hygienische Situation deines Bestandes zuverlässig einschätzen möchtest – sowohl bei Legehennen als auch bei Mast- und Schlachttieren.
Der Salmo-Check eignet sich für:
1. Hobby- und Gartenhühnerhalter (freiwillige Kontrolle)
• zur regelmäßigen freiwilligen Prüfung der Eihygiene, wenn du oder deine Familie die Eier selbst verzehren
• zur Sicherheit bei Abgabe kleinerer Mengen an Nachbarn, Freunde oder Hofkunden
• als Statuskontrolle nach Neuzugängen oder bei auffälligen Stallbefunden
• als Teil eines guten Hygienemanagements im Hobbybestand
2. Kleine Mobilställe und Direktvermarkter (freiwillige Kontrolle)
• zur hygienischen Absicherung beim Eierverkauf oder bei der Fleischvermarktung in Kleinmengen
• zur Dokumentation gegenüber Kunden (zum Beispiel: „Letzte Salmonellenprobe: negativ“)
• bei Beständen mit Kundenkontakt, Kinderbauernhöfen oder pädagogischen Angeboten
• als interne Qualitätssicherung, auch wenn der Bestand nicht über dem gesetzlichen Schwellenwert liegt
3. Gewerbliche Betriebe – wenn die Probenpflicht greift
Falls dein Betrieb unter die Geflügel-Salmonellen-Verordnung (GflSalmoV) fällt, kannst du den Salmo-Check zur Erfüllung deiner Eigenkontrollen nutzen:
• Legehennenbetriebe ab 350 Hennen – Pflicht zur regelmäßigen Beprobung gemäß GflSalmoV (wenn keine Ausnahme besteht).
• Masthähnchenbestände ab 5.000 Tieren – Probenahme etwa 3 Wochen vor der Schlachtung
Der Salmo-Check kann hier als betriebliche Kontrollprobe dienen – ideal für Mobilställe und wachsende Betriebe, die sich an die verpflichtende Eigenkontrolle herantasten oder diese sauber dokumentieren möchten.
Mit dem Salmo-Check wird deine Stallprobe auf alle für’s Geflügel relevanten Salmonellen-Serovare untersucht. Das bedeutet: Es wird nicht nur nach einer einzelnen „Salmonellen-Art“ gesucht, sondern immer nach allen Serovaren, die bei Hühnern und anderem Geflügel eine Rolle spielen.
Relevante Serovare sind zum Beispiel:
• Salmonella Enteritidis
• Salmonella Typhimurium (inklusive monophasischer Varianten)
• Salmonella Infantis
• Salmonella Hadar
• Salmonella Virchow
Du bekommst ein klares Laborergebnis, ob in der eingesendeten Probe Salmonellen nachweisbar sind oder nicht.
Die Probenentnahme erfolgt mit speziellen Boot-Swabs. Sie nehmen beim Kontakt mit dem Boden zuverlässig Material aus dem Stall auf. So erhältst du eine repräsentative Probe aus der gesamten Umgebung – ganz ohne Stress für deine Hühner.
Wenn dein Stall begehbar ist, gehst du so vor:
- Handschuhe und normale Überziehschuhe anziehen.
- Die feuchten Swab-Boots über die Überziehschuhe ziehen.
- Den Stall oder die Voliere in eine Richtung gleichmäßig ablaufen.
- Swab-Boots ausziehen und in den Probenbeutel geben.
- Das zweite Paar Bootswabs anziehen und den Rückweg im Stall ablaufen, dann ebenfalls in den Probenbeutel geben.
Wenn der Stall nicht begehbar ist (z. B. kleine Gruppenhaltung,geringe Deckenhöhe):
- Handschuhe anziehen.
- Swab-Boots wie Handschuhe über die Hände ziehen.
- Mit den „Hand-Swabs“ die erreichbaren Stallflächen, Einstreu und Laufwege großflächig abtupfen.
- Swabs in den Probenbeutel legen.
Der gefüllte Probenbeutel wird anschließend in den Rücksendekarton gelegt, sicher verschlossen und wie beschrieben zurückgeschickt.
Der Vorteil dieser Methode: Du beprobtest besonders viel Stallfläche und erhältst dadurch eine sehr aussagekräftige Stallprobe – komplett stressfrei für deine Tiere.
- 2 Paar angefeuchtete Boot-Swabs
- 1 sicherer Verschlussbeutel
- Anleitung zur Aktivierung und Probenentnahme
- vorfrankierte Rücksendebox














